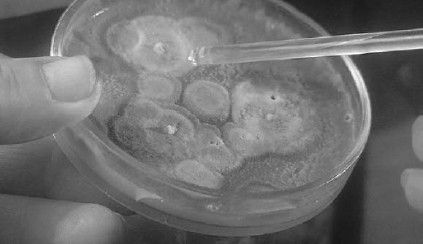
Леонид Рудницкий - Плесень - лекарство или яд?

Глава 3
Плесень лечит, или Гимн человечества плесени
Человечество спасла неряшливость ученого
Открытие Флемингом пенициллина в 1928 году было счастливой случайностью и явилось результатом стечения ряда обстоятельств столь невероятных, что в них почти невозможно поверить. Коллеги бактериолога после работы очищали чашки с бактериальными культурами. Флеминг не отличался аккуратностью, поэтому его бактерии "зрели" в чашках по 2–3 недели, пока не покрывались плесенью. Только когда стол был весь заставлен заплесневелыми чашками, Флеминг начинал заниматься уборкой. Он просматривал культуры одну за одной: а вдруг появится что-нибудь интересное?! И оно появилось! В одной из чашек он обнаружил плесень, которая смело вытесняла высеянную культуру бактерии стафилококка. Начав исследовать новую плесень, он выяснил, что те микроорганизмы, на которых разрослась плесень, приобрели способность подавлять рост других микроорганизмов, а также приобрели и бактериологические свойства по отношению ко многим распространенным патогенным бактериям.

Рис. 18. Плесень – спасительница человечества
Цепочка счастливых случайностей
Автор книги "Шеренга великих медиков" Гжегош Федоровский пишет: "Из коридора через приоткрытую в маленькую, тесную лабораторию дверь можно было видеть доктора Александра Флеминга, суетившегося в тесном, заставленном множеством вещей помещении. Вот он переставляет с места на место чашки Петри, тщательно осматривает их и сортирует по каким-то, одному ему известным, признакам. Ему необходимо написать для учебника бактериологии главу о стрептококках. Для этого ему надо провести ряд опытов на многочисленных колониях этих микробов. Он наполняет чашки Петри агар-агаром, который, остывая, образует на дне плиток гладкую пленку; на нее он помещает культуру бактерий. В этой превосходной питательной среде при соответствующей температуре бактерии развиваются и образуют крупные колонии, похожие на разветвленные комки янтарного цвета.
В лаборатории Флеминга его ужаснейшим врагом была плесень. Обыкновенная зеленовато-серая плесень, которая берется неведомо откуда во влажных углах плохо проветриваемых помещений, покрывает несвежие продовольственные продукты, если их плохо хранят. Плесень – это не что иное, как микроскопический грибок, возникающий из еще меньших зародышей, тысячи которых носятся в воздухе. Как только зародыши попадают в благоприятную для них среду, они начинают очень быстро разрастаться.
Флеминг не раз, поднимая крышку чашки Петри, с досадой убеждался, что культуры стрептококков загрязнены плесенью. И действительно, в лаборатории достаточно было оставить чашку Петри на несколько часов без крышки, как весь питательный слой покрывался плесенью. Немалых трудов стоила Флемингу борьба с нежелательными примесями то на одной, то на другой плитке. Как-то на одной из чашек Флеминг увидел странное явление и долго присматривался к нему. Чашку покрывала плесень, но, в отличие от других чашек, здесь вокруг колонии бактерий образовалась небольшая круглая лысинка. Возникало впечатление, что бактерии не размножались вокруг плесени, хотя на остальной поверхности агар-агара, на некотором расстоянии от плесени, бактерии разрослись, притом довольно сильно.
"Случайность или закономерность?" – задумался Флеминг…"
Рис. 19. Плесень, которая убивает бактерии
Неряшливость Флеминга и сделанное им наблюдение явились всего лишь двумя обстоятельствами в целом ряду случайностей, способствовавших открытию. Плесень, которой оказалась заражена культура, относилась к очень редкому виду Penicillium. Вероятно, она была занесена из лаборатории, расположенной этажом ниже, где выращивались образцы плесени, взятые из домов больных, страдающих бронхиальной астмой, с целью изготовления из них десенсибилизирующих экстрактов. Флеминг оставил ставшую впоследствии знаменитой чашку на лабораторном столе и уехал отдыхать. Наступившее в Лондоне похолодание создало благоприятные условия для роста плесени, а наступившее затем потепление – для бактерий. Как выяснилось позднее, стечению именно этих обстоятельств мир обязан знаменитым открытием.
Из микроскопического кусочка плесени Флеминг получил большую колонию. Потом он помещал часть этой плесени в чашки, где культивировал разные бактерии. Оказалось, что некоторые виды бактерий прекрасно уживаются с плесенью, но стрептококки и стафилококки в присутствии плесени не развивались.
Многочисленные ранние опыты с размножением вредоносных бактерий показали, что некоторые из них способны уничтожать других и не допускают их развития в общей среде. Это явление было названо "антибиозом" от греческого "анти" – против и "биос" – жизнь. Работая над поиском действенного противомикробного средства, Флеминг об этом прекрасно знал. У него не было никаких сомнений, что в чашке с таинственной плесенью он встретился с явлением антибиоза. Он начал тщательно исследовать плесень. Спустя некоторое время ему удалось даже выделить из плесени противомикробное вещество. Поскольку плесень, с которой он имел дело, носила видовое латинское название Penicilium notatum, полученное вещество он назвал пенициллином.
Первые успехи и поражения пенициллина
Гжегож ФЕДОРОВСКИЙ в своей книге "Плеяда великих медиков" приоткрывает завесу над тем, как разворачивались события дальше. "Ассистент Флеминга, доктор Стюарт Греддок, заболевший гнойным воспалением так называемой гайморовой полости, был первым человеком, который решился принять дозу пенициллина. Ему ввели в полость небольшое количество вытяжки из плесени, и уже через три часа можно было убедиться, что состояние его здоровья значительно улучшилось.
Было ясно, что Флеминг выиграл крупное сражение с бактериями. Но война человечества с микробами еще не закончилась: необходимо было разработать промышленные методы производства пенициллина. Над этой проблемой Флеминг работал больше двух лет, но успеха не добился. Этим и объясняется факт, что первая статья с сообщением о противомикробных свойствах пенициллина была написана Флемингом спустя три года после окончания опытов по его практическому применению.
Первоначальные исследования Флеминга дали ряд важных сведений о пенициллине. Он писал, что это "эффективная антибактериальная субстанция, оказывающая выраженное действие на пиогенные кокки (гноеродные Staphylococcus и Streptococcus) и палочки дифтерийной группы… Пенициллин даже в огромных дозах не токсичен для животных… Можно предположить, что он окажется эффективным антисептиком при наружной обработке участков, пораженных чувствительными к пенициллину микробами, или при его введении внутрь". Зная это, Флеминг, как ни странно, не сделал столь очевидного следующего шага, который 12 лет спустя был предпринят Хоуардом У. Флори и состоял в том, чтобы выяснить, будут ли спасены мыши от летальной инфекции, если лечить их инъекциями пенициллинового бульона. Флеминг лишь назначил его нескольким пациентам для наружного применения. Однако результаты были противоречивыми и обескураживающими. Раствор не только с трудом поддавался очистке, но и оказывался нестабильным в случае его массового производства".
На грани безвестности
Подобно Пастеровскому институту в Париже, отделение вакцинации в больнице св. Марии, где работал Флеминг, существовало благодаря продаже вакцин. Флеминг обнаружил, что в процессе приготовления вакцин пенициллин помогает предохранить культуры от стафилококка. Это было небольшое техническое достижение, и ученый широко пользовался им, еженедельно отдавая распоряжение изготовить большие партии бульона. Он делился образцами культуры Penicillium с некоторыми коллегами в других лабораториях, но ни разу не упомянул о пенициллине ни в одной из 27 статей или лекций, опубликованных им в 1930–1940 годах, даже если речь в них шла о веществах, вызывающих гибель бактерий.
Пенициллин, возможно, был бы навсегда забыт, если бы не более раннее открытие Флемингом лизоцима, ведь и попытки промышленного производства пенициллина, осуществленные другими исследователями, тоже были безуспешны. Но вот в середине 1939 года два ученых из Оксфорда: врач Хоуард У. Флори и химик Дж. Эрнест Чейн – взялись за это дело. После двух лет разочарований и поражений им удалось получить несколько граммов коричневого порошка, который уже можно было испытать на людях. Это был хотя и не совсем чистый, но достаточно качественный кристаллический пенициллин.
Пенициллин: жизнь в подполье
Для нации важность этого открытия во время войны была очевидна. Однако то время (июль 1940 года) было неблагоприятным, поскольку Лондон бомбили и существовала угроза вторжения немцев в Великобританию. Производить пенициллин пришлось в лаборатории патологии Оксфордского университета. Настроение того времени можно понять по тому, что было принято решение уничтожить аппаратуру для получения пенициллина и важнейшие документы, если захватчики достигнут Оксфорда, но продуктивный штамм плесени Penicillium должен был быть сохранен. С этой целью несколько основных работников нанесли споры плесени на свою одежду, где они могли сохраниться в течение нескольких лет, и любой из членов группы, которому удалось бы спастись в этой одежде, мог их использовать и вновь начать работу.